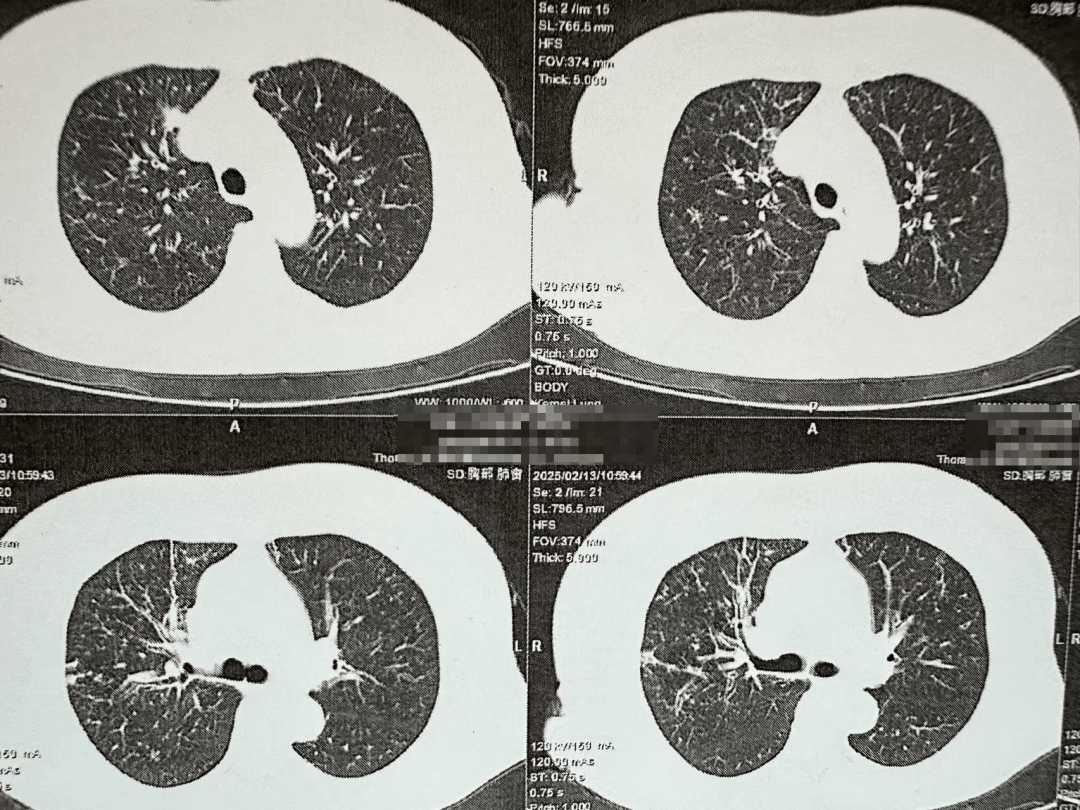
图片

院内新闻
【疑难诊治看二院】七旬老太高烧月余命悬一线,市二院呼吸与危重症医学科揪出“伪装者”——非HIV肺孢子菌肺炎!
前情提要
73岁的张阿姨从未想过,一场“普通”发热竟让她在鬼门关前走了一遭。持续39℃高热、四种抗生素轮番上阵、四次CT扫描反复排查,1个多月的奔波让张阿姨身心疲惫。直到家属带着最后希望来到葫芦岛市第二人民医院呼吸与危重症医学科,这场“发热持久战”才终于在宋刚主任的诊断下落下帷幕。
PART.01
精准诊断 揭秘高烧背后的真相
“这不是普通肺炎!这种对常规抗生素无反应的肺炎,需要警惕特殊病原体感染。”有着20年疑难肺部感染诊疗经验的宋主任立即警觉,并当机立断安排支气管镜检查。由于连日病痛折磨,患者身体素质较差,当支气管镜探入气道瞬间,患者突发急性呼吸衰竭,医护团队上演“生死时速”——一边加压给氧维持生命体征,一边精准完成肺泡灌洗。结果震惊所有人——肺孢子菌肺炎(PCP),一种通常见于HIV感染者的罕见肺炎。
在明确诊断后,宋刚主任为患者进行对症治疗,39℃的高热在精准治疗下72小时内退至正常。劫后余生的张阿姨握着宋主任的手哽咽:“被罕见病找上是不幸,遇到宋主任就是不幸中的万幸,原本以为熬不过这个夏天了!”
PART.02
非HIV-PCP患者的致命危机
肺孢子菌肺炎(PCP)曾是艾滋病患者的“专属杀手”,但近年来,类风湿等自身免疫病人群、长期使用免疫抑制剂者、恶性肿瘤化疗后人群等非HIV免疫缺陷人群的发病率显著上升。这类患者因免疫系统“破防”,极易感染肺孢子菌,而常规痰检的阳性率不足10%,导致多数患者被误诊为普通肺炎,错过黄金治疗期。
非HIV-PCP肺部影像
非HIV-PCP的早期症状与普通肺炎相似,但进展更快,48小时内可能引发呼吸衰竭。有免疫缺陷病史(如肿瘤化疗、器官移植、风湿免疫病长期用药)等高危人群一旦出现持续发热>1周,抗生素治疗无效;干咳、进行性呼吸困难;血氧饱和度<93%等症状应立即到呼吸与危重症医学科就医,进行支气管镜肺泡灌洗检查。
作为“国家呼吸与危重症医学科(PMCC)规范化建设单位”,省内首批“国家呼吸医疗质量与管理哨点医院”,市二院呼吸与危重症医学科建设工作达到国家级标准、规范化水平,擅长经支气管镜下诊疗和“无痛”支气管镜诊疗技术,为呼吸系统疾病提供更加有效的诊疗手段,让更多被呼吸系统疑难疾病困扰的患者重新找到希望!
PART.03
人民医院 人民名医
宋刚
主任医师
·葫芦岛市第二人民医院呼吸与危重症医学科主任
·辽宁省生命科学学会东北呼吸与危重症医学(PCCM)分会辽宁省基层委员会副主任委员
·辽宁省细胞生物学学会放射粒子治疗专业委员会理事
·辽宁省抗击新冠肺炎疫情先进个人
·葫芦岛市劳动鉴定委员会专家库成员
·葫芦岛市医学会呼吸内科学分会第三届委员会副主任委员
专业特色:擅长呼吸系统疑难及急危重患者的救治,如急慢性支气管炎、支气管哮喘、慢性阻塞性肺疾病、肺炎、肺栓塞、肺癌、间质性肺疾病、睡眠呼吸暂停综合征等,尤其擅长有创无创机械通气、支气管镜下相关检查及治疗(TBNA、气道支架置入术、球囊扩张等)、全肺灌洗术等领先技术,发表国家级期刊多篇。

上一篇:【全国百强名医亲诊】市二院神经外科桑文渊主任携手三博脑科医院闫长祥教授完成高难度巨大听神经瘤手术 下一篇:【技术领航】七旬阿姨突发麻木竟是动脉瘤作祟,神经介入科钟强主任联合北京专家创新应用血流导向装置制伏颅内“隐形杀手”









 统一呼叫平台
统一呼叫平台